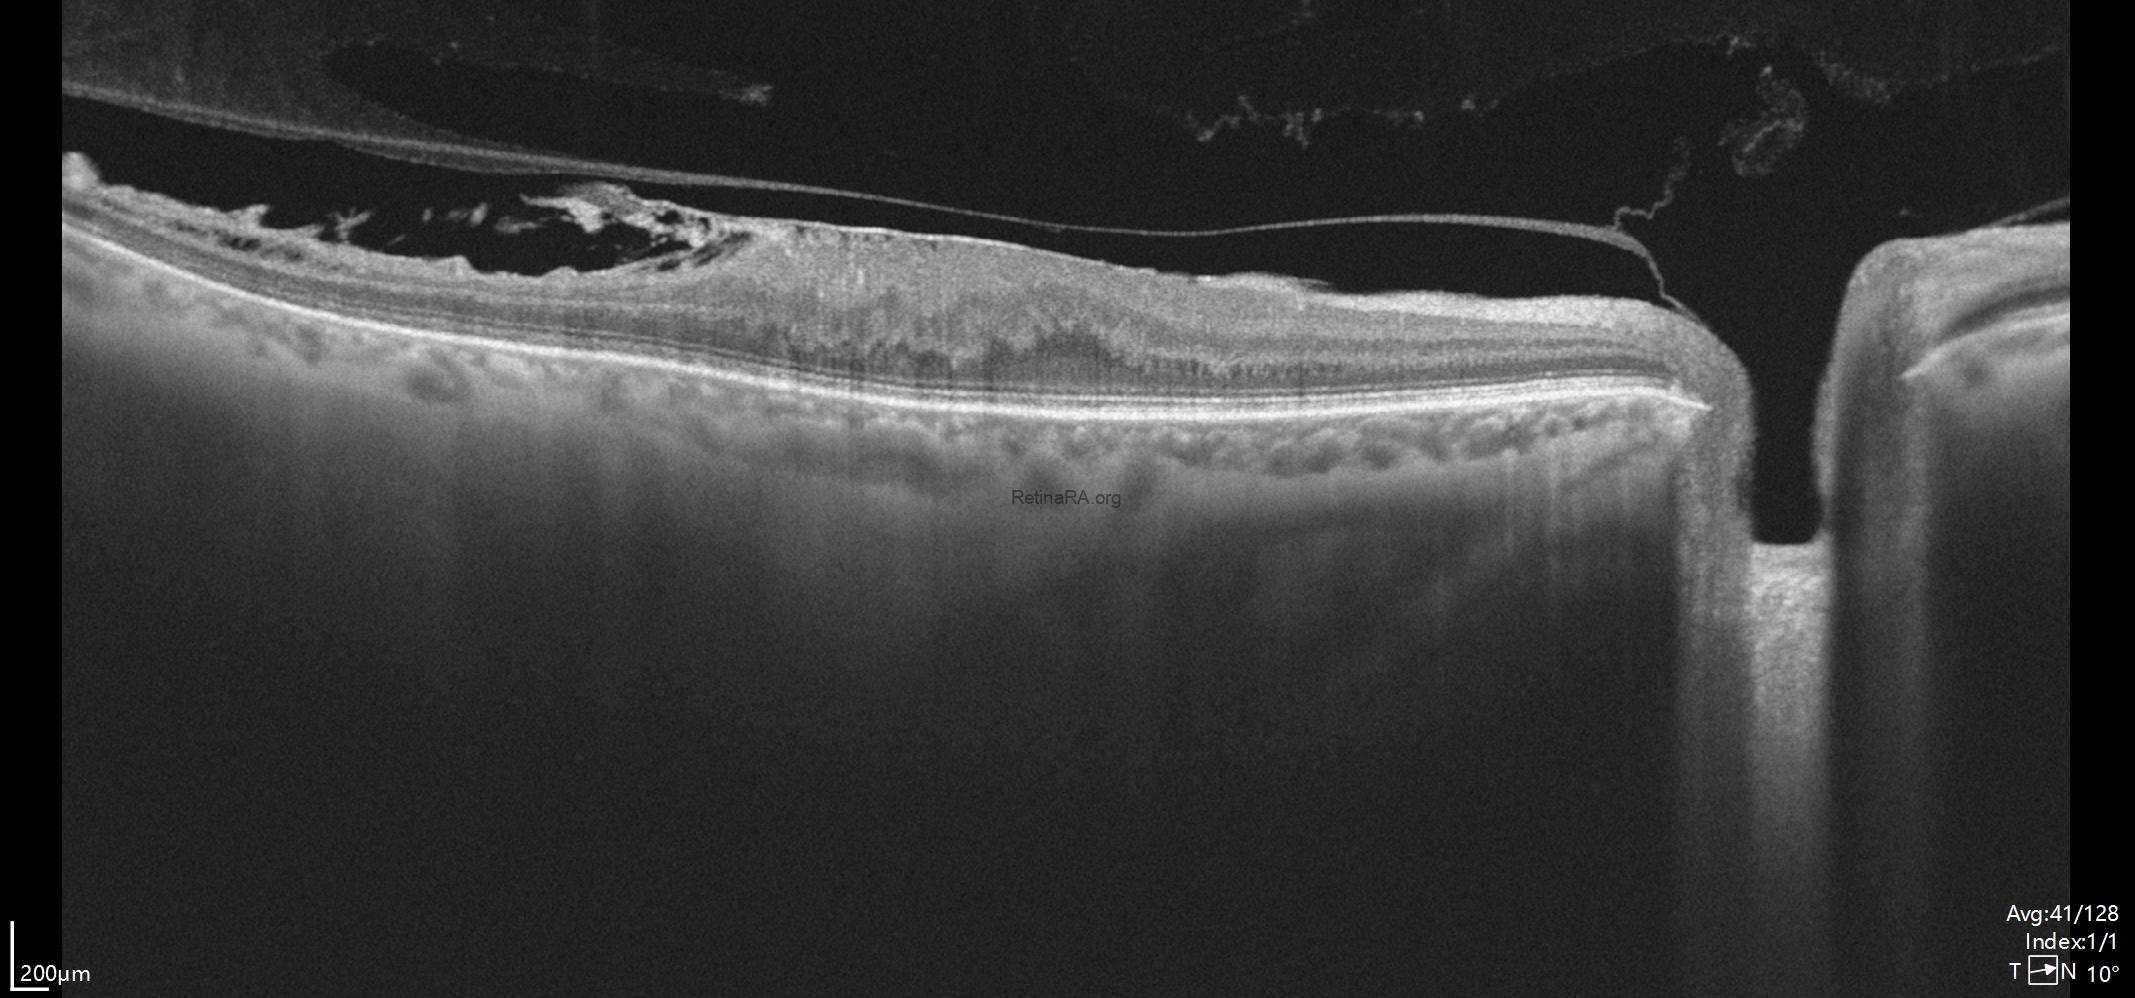
tightly-adherent-erm-3
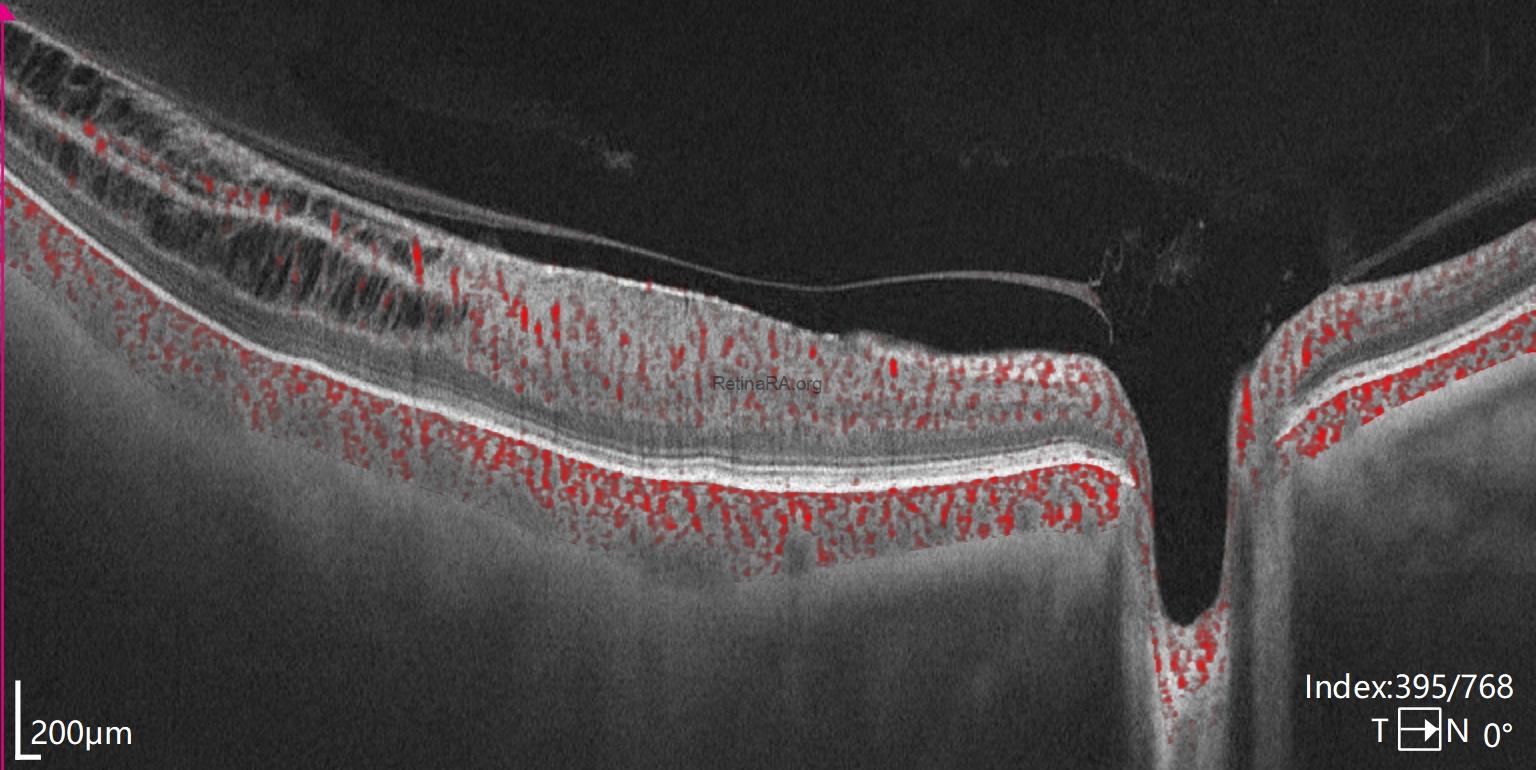
tightly-adherent-erm-1
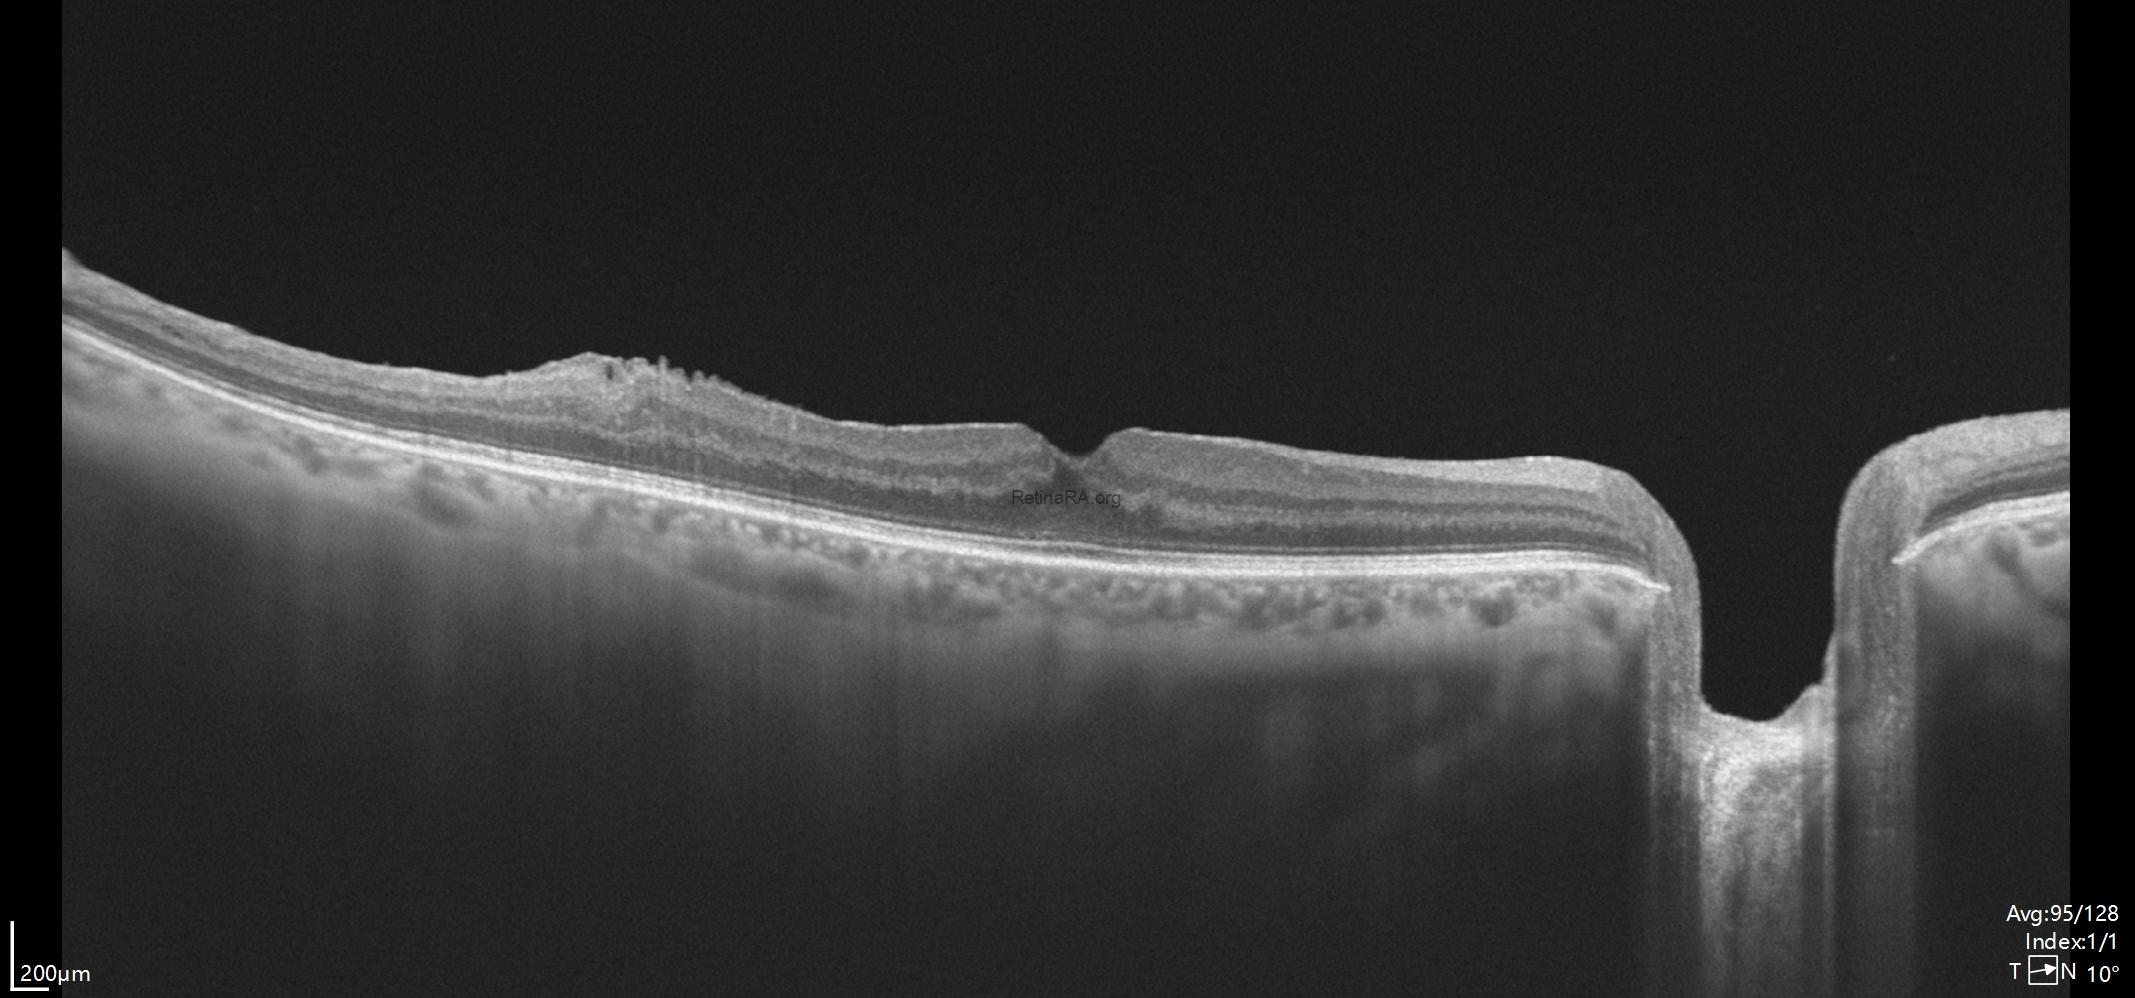
postoperative-tightly-adherent-ERm-2

This post presents a case of a tightly adhered epiretinal membrane and pre-existing retinal damage.
A 61-year-old male patient whose vision in his right eye has decreased for the last 2 years.
In some other clinics, he was advised that vitrectomy surgery might be risky and postoperative vision could potentially worsen. When the patient presented to the surgeon, his visual acuity in the right eye was 20/50. He also had a very mild cataract.
As seen in the color fundus photograph, there was significant tangential macular traction, particularly at the temporal side. Enface OCT demonstrated this remarkably well. It clearly showed the contraction of the epiretinal membrane, distortion of the retina, and traction-related retinal damage.


B-scan OCT shows us the loss of foveal depression due to ERM. In the upper scan, the posterior hyaloid appears attached to the optic disc. The lower OCT scan shows that, the posterior hyaloid remains attached to the retina in the temporal macular region where the retinoschisis appearance and damaged retina were present.
In the upper OCT, marked thinning of the temporal retina was visible. Disruptions were observed especially within the retinal nerve fiber layer and the ganglion cell layer.

The surgeon performed cataract and vitrectomy surgery along with an ERM peel procedure. As per the pre-operative plan, he did not peel off any pre-existing retinal damage.
Five month after surgery, restoration of the foveal depression was observed. Even in the temporal macular region where a portion of the membrane was intentionally left, the retinal architecture showed a significant improvement compared to the preoperative state. Visual acuity improved to 20/20.

The YouTube video provides a detailed explanation of the surgery (click here to watch the video).
Credit: M. Giray Ersoz, MD, FEBO
Memorial Hospital, Department of Ophthalmology, Istanbul, Turkey
Arel University School of Medicine, Department of Ophthalmology, Istanbul, Turkey
Instagram accounts: @retina.review and @retina.dr.girayersoz

